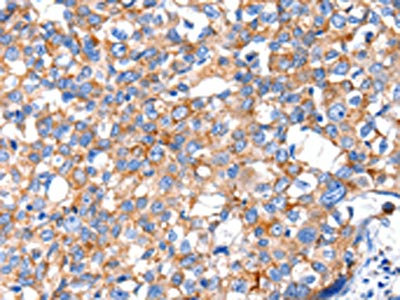

KLK15 Antibody
-
中文名稱:KLK15兔多克隆抗體
-
貨號:CSB-PA039843
-
規格:¥1100
-
圖片:
-
The image on the left is immunohistochemistry of paraffin-embedded Human breast cancer tissue using CSB-PA039843(KLK15 Antibody) at dilution 1/15, on the right is treated with fusion protein. (Original magnification: ×200)
-
The image on the left is immunohistochemistry of paraffin-embedded Human gastric cancer tissue using CSB-PA039843(KLK15 Antibody) at dilution 1/15, on the right is treated with fusion protein. (Original magnification: ×200)
-
Gel: 12%SDS-PAGE, Lysate: 40 μg, Lane 1-2: 231 cells, HT29 cells, Primary antibody: CSB-PA039843(KLK15 Antibody) at dilution 1/200, Secondary antibody: Goat anti rabbit IgG at 1/8000 dilution, Exposure time: 1 minute
-
-
其他:
產品詳情
-
Uniprot No.:
-
基因名:KLK15
-
別名:KLK15 antibody; Kallikrein-15 antibody; EC 3.4.21.- antibody; ACO protease antibody
-
宿主:Rabbit
-
反應種屬:Human
-
免疫原:Fusion protein of Human KLK15
-
免疫原種屬:Homo sapiens (Human)
-
標記方式:Non-conjugated
-
抗體亞型:IgG
-
純化方式:Antigen affinity purification
-
濃度:It differs from different batches. Please contact us to confirm it.
-
保存緩沖液:-20°C, pH7.4 PBS, 0.05% NaN3, 40% Glycerol
-
產品提供形式:Liquid
-
應用范圍:ELISA,WB,IHC
-
推薦稀釋比:
Application Recommended Dilution ELISA 1:2000-1:5000 WB 1:200-1:1000 IHC 1:25-1:100 -
Protocols:
-
儲存條件:Upon receipt, store at -20°C or -80°C. Avoid repeated freeze.
-
貨期:Basically, we can dispatch the products out in 1-3 working days after receiving your orders. Delivery time maybe differs from different purchasing way or location, please kindly consult your local distributors for specific delivery time.
-
用途:For Research Use Only. Not for use in diagnostic or therapeutic procedures.
相關產品
靶點詳情
-
功能:Protease whose physiological substrate is not yet known.
-
基因功能參考文獻:
- KLK15 may be able to cleave many ECM components, similar to several members of the KLK family. Thus the protease could potentially be linked to tumorigenesis by promoting metastasis via this mechanism. PMID: 29928903
- Data provide insights into the localization and possible role of KLK15 in human physiology. PMID: 29958881
- Pronounced correlations between KLK10/KLK11 (rs = 0.647) and between KLK9/KLK15 (rs = 0.716) mRNA, but not between other combinations, indicate coordinate expression of distinct pairs of peptidases PMID: 29095848
- Variations in KLK15, but not KLK11 expression were significantly associated with prognosis in gastric cancer PMID: 26224476
- Advanced pathologic stage was associated with significantly higher expression of KLK15 and PCA3 mRNAs. PMID: 23391636
- KLK15 mRNA expression levels are a novel marker for the differential diagnosis of prostate cancer. PMID: 23620432
- These findings suggest a role for KLK15 genetic variation in the etiology of prostate cancer among men of European ancestry. PMID: 22132073
- association with ovarian cancer survival PMID: 21457553
- Multivariate analysis identified dichotomised KLK15 expression, corrected for patient parameters age, preoperative prostate-specific antigen level, pathological tumour stage, Gleason score and surgical margins, as an prognostic factor for poor outcome. PMID: 20473923
- KLK15 expression analysis could be employed as a valuable tool for the discrimination between benign prostatic hyperplasia and prostate cancer tissue specimens and as an unfavorable prognostic marker for prostate cancer. PMID: 20067463
- Data show six non-synonymous amino acid or frame shift changes in the KLK3 gene and three changes in each of the neighboring genes, KLK15 and KLK2. PMID: 19823874
- Kallikrein 15 expression is an independent prognostic factors of progression-free and overall survival in breast cancer patients PMID: 12439720
- KLK15 expression, as assessed by quantitative RT-PCR, is an independent marker of unfavorable prognosis for ovarian cancer. PMID: 12915603
顯示更多
收起更多
-
亞細胞定位:Secreted.
-
蛋白家族:Peptidase S1 family, Kallikrein subfamily
-
組織特異性:Highest expression in the thyroid gland. Also expressed in the prostate, salivary, and adrenal glands and in the colon testis and kidney.
-
數據庫鏈接:
Most popular with customers
-
-
YWHAB Recombinant Monoclonal Antibody
Applications: ELISA, WB, IHC, IF, FC
Species Reactivity: Human, Mouse, Rat
-
Phospho-YAP1 (S127) Recombinant Monoclonal Antibody
Applications: ELISA, WB, IHC
Species Reactivity: Human
-
-
-
-
-